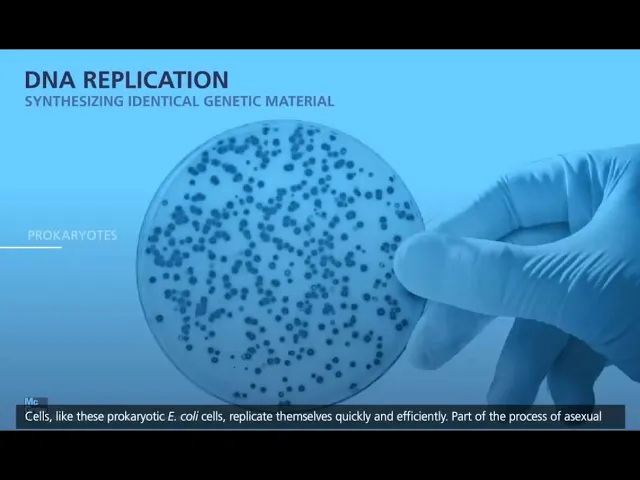

as células como essas células e cole procarióticas podem replicar-se rapidamente e com muita eficiência parte do processo de reprodução assexuada é a capacidade das células em fazer cópias idênticas do seu DNA antes da divisão celular ocorrer células procarióticas que se reproduzem por fissão binária o fazem com base na precisão e velocidade com que a replicação do DNA ocorre para garantir que as gerações futuras terão as mesmas instruções genéticas que as células-mãe a estrutura do DNA ajuda na velocidade e precisão da replicação um DNA de dupla fita é um polímero de duas cadeias de nucleotídeos conectadas
por ligações de hidrogênio para formar uma dupla hélice os nucleotídeos são moléculas que consistem em um açúcar a desoxirribose um fosfato e uma das quatro bases nitrogenadas a coluna vertebral de cada fita consiste em grupos alternados de açúcar e fosfato ligadas por ligações fosfodiéster as bases nitrogenadas incluem citosina timina adenina e guanina citosina forma três ligações de hidrogênio com a guanina EA time na forma duas ligações de hidrogênio com adenina isso é chamado de pareamento por base complementar a dupla hélice tem uma fita orientada em uma direção cinco linha para três linhas em relação ao
grupo hidroxila da desoxirribose e a outra fita é orientada na direção três linhas para cinco linha é isso mostra a natureza antiparalela do DNA e o pareamento de bases complementares na estrutura do DNA permite aqui a replicação seja executada de uma maneira semi-conservativa cada fita da molécula de DNA é usada como molde para a criação de uma nova dupla fita e a replicação começa com a fita dupla de DNA sendo separada e cada fita original chamadas de fita parental sendo usada como molde para o pagamento complementar dos nucleotídeos para criar duas novas moléculas de DNA
A replicação do DNA ocorre na direção cinco linhas para três linhas adicionando novos nucleotídeos na extremidade três linhas na nova fita formada e a replicação do DNA começa em sítios específicos chamados de origem da replicação a origem da replicação denota uma área de replicação ativa chamada Forquilha de replicação e e para compreendermos como organismos eucarióticos complexos replicam o DNA os cientistas estudam a replicação em organismos modelo procarióticos como a e cole um grande número de enzimas é necessário para que a replicação ocorra a cinta Forquilha de replicação é estabelecida E aí ele Case separa as
fitas de DNA desfazendo a dupla hélice e as proteínas de ligação a fita simples estabilizam essa nova região de fita simples a DNA girase garante que as áreas de dupla fita fora da Forquilha de replicação Não fiquem excessivamente torcidas assim que a Forquilha de replicação é estável a DNA polimerase que catalisa a adição de novos nucleotídeos na nova fita em crescimento outras proteínas como as betaplan pis e as Clube lodders ajudam a estabilizar a DNA polimerase sobre a molécula de DNA pequenas sequências de RNA chamados de primers ou iniciadores precisam ser pareados com a fita
molde pela enzima primazzi porque a DNA polimerase não consegue adicionar novos nucleotídeos em uma dupla a replicação de ambas as fitas ocorre ao mesmo tempo em uma a simples e ocorre de maneira contínua e na outra desconte no a síntese continua ocorre na a linha para cinco linha da fita parental que chamamos de fita Líder os novos nucleotídeos são adicionados na extremidade três linhas que está continuamente expandindo a Forquilha de replicação a síntese desses continua ocorre na fita parental que está orientada na direção cinco linhas para três linhas chamada de fita e é feita em
segmentos chamados de fragmentos de okazaki a replicação nessa fita usa a primazzi para adicionar um primer à frente da extremidade cinco linhas da fita então a DNA polimerase 3 adiciona pequena sequência de nucleotídeos os fragmentos de okazaki desde o Primer preenchendo a lacuna E à medida que a hélice continua a ser aberta esse processo se repete até que toda a fita seja replicada e a DNA polimerase tipo um substitui os nucleotídeos de RNA dos primers com nucleotídeos de DNA EA DNA ligase catalisa a ligação entre os fragmentos e os nucleotídeos substituídos assim que a fita
líder e a finalizam a sua replicação duas cópias idênticas da molécula de DNA são produzidas no processo de replicação do DNA permite que as bactérias em divisão celular garantam que todas as células filhas tenham as mesmas instruções genéticas que a célula-mãe permitindo a elas funcionar da mesma maneira assim as populações de bactérias podem crescer aumentando o número de indivíduos na colônia